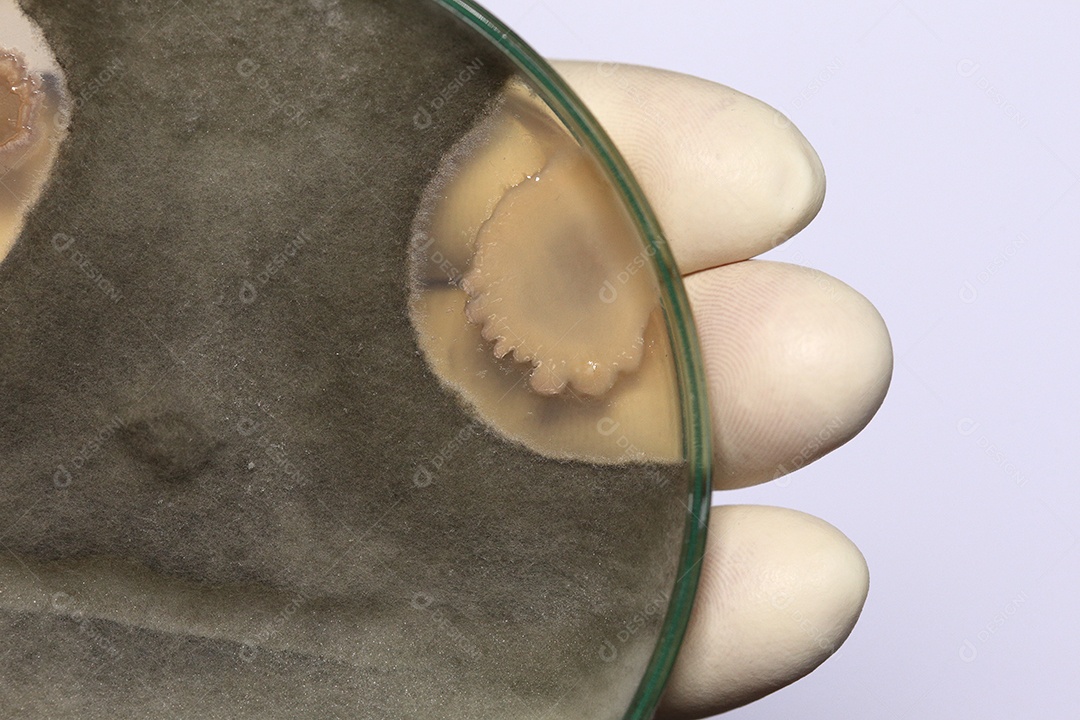
Microscópio fungos bactérias

Informações:
- Formato do arquivo: JPG
- Extensão de download: jpg
- Tamanho: 18.64 MB
- Número de identificação: #10481476
- Licença: Premium
Este é um recurso que está disponível oferecido em formato JPG. Este é um dos formatos de imagem mais utilizados no mundo, conhecido por sua alta compatibilidade e qualidade visual, ideal para projetos digitais e impressos. O arquivo possui tamanho de 18.64 MB e está disponível sob a licença Premium. Esta licença permite o uso do recurso tanto em projetos pessoais quanto comerciais.




















